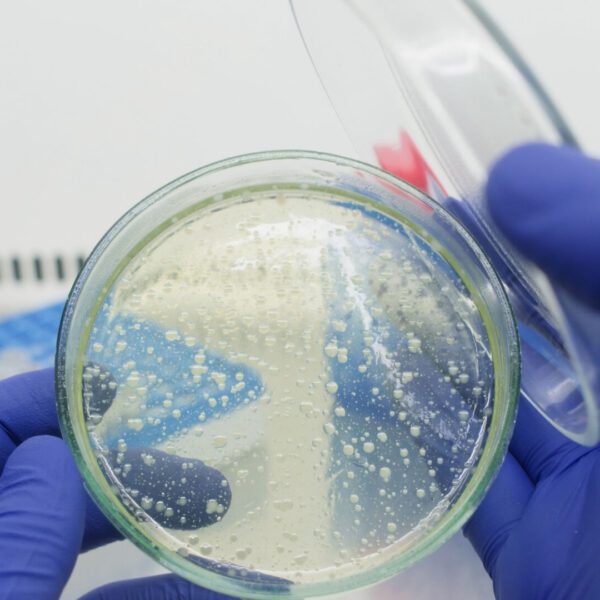

Opportunities from Partners and Industry
Learn about opportunities, funding, grants, and more currently available from our partners and industry. If you have relevant opportunities that you would like to advertise, please contact us.
You can view current biofilm PhD opportunities on the FindAPhD website.
Current Opportunities
Aarhus University PhD: Catalytic DNA in Biofilms
Applications are invited for a PhD fellowship/scholarship in Catalytic DNA in Biofilms at Graduate School of Natural...
Southampton PhD: Microbiologically Influenced Corrosion Associated with Marine Fouling
Microbiologically Influenced Corrosion Associated with Marine Fouling About the project Microbiologically-influenced...
NBIC Mentoring Programme 2025–2026
Join the NBIC Mentoring Programme 2025–2026 We are launching our first NBIC Mentoring Programme for 2025-2026 and we...
Biofilm Alliance Implementation Phase Survey
Are you engaged in biofilm research, regulation, or industry applications? Your expertise is crucial in shaping the...
Knowledge Transfer Partnerships (KTPs) Programme
Since 1975, Knowledge Transfer Partnerships (KTPs) have been helping businesses and organisations innovate for growth....
UK Innovation and Science Seed Fund (UKI2S)
The UK Innovation and Science Seed Fund (UKI2S) invests in innovations from the UK’s science and knowledge base,...